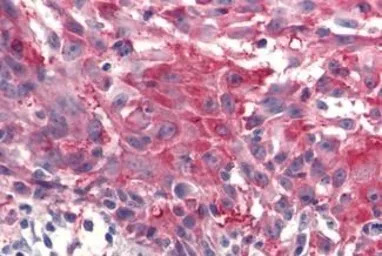
Frizzled 4 antibody

相关产品推荐更多 >
万千商家帮你免费找货
0 人在求购买到急需产品
- 详细信息
- 文献和实验
- 技术资料
- 免疫原:
Synthetic 13 amino acid peptide from C-terminus of human FZD4 / Frizzled 4.
- 亚型:
IgG
- 形态:
Liquid
- 保存条件:
Store as concentrated solution. Centrifuge briefly prior to opening vial. For short-term storage (1-2 weeks), store at 4ºC. For long-term storage, aliquot and store at -20ºC or below. Avoid multiple freeze-thaw cycles.
- 克隆性:
Polyclonal
- 标记物:
Unconjugated
- 适应物种:
Human, Mouse, Rat, Rabbit, Bovine, Dog, Hamster, Chicken, Pig, Monkey, Bat, Horse
- 保质期:
12 months from the shipping date of the product.
- 抗原来源:
Human
- 目录编号:
GTX12992
- 级别:
Primary Antibodies
- 库存:
Available
- 供应商:
GeneTex
- 宿主:
Rabbit
- 应用范围:
IHC-P
- 浓度:
1 mg/ml (Please refer to the vial label for the specific concentration.)
- 靶点:
Frizzled 4
- 抗体英文名:
Frizzled 4 antibody
- 抗体名:
Frizzled 4 抗体
- 规格:
25 μg

IHC-P analysis of human kidney tissue using GTX12992 Frizzled 4 antibody.
Antigen retrieval : Heat-induced antigen retrieval

IHC-P analysis of human pancreas, carcinoma tissue using GTX12992 Frizzled 4 antibody.
Antigen retrieval : Heat-induced antigen retrieval
IHC-P analysis of human skin, melanoma tissue using GTX12992 Frizzled 4 antibody.
Antigen retrieval : Heat-induced antigen retrieval
风险提示:丁香通仅作为第三方平台,为商家信息发布提供平台空间。用户咨询产品时请注意保护个人信息及财产安全,合理判断,谨慎选购商品,商家和用户对交易行为负责。对于医疗器械类产品,请先查证核实企业经营资质和医疗器械产品注册证情况。
 文献和实验
文献和实验v468.Chapter 3 分泌型跨膜相关蛋白提纯及Wnt抑制活性
Purification and Wnt-Inhibitory Activities of SecretedFrizzled-Related Proteins Methods in Molecular Biology v468. chapter Abstract Recombinant expression of secreted Frizzled-related proteins (sFRPs) in mammalian expression systemsis
受损[8]。 更隐蔽的是,AβO 会促进 Wnt 拮抗剂 Dkk1 表达,竞争性阻断 Wnt 与 Frizzled 受体结合,使 β-catenin 被 GSK3β 磷酸化降解,从而抑制 Wnt/β-catenin 通路——这一通路对突触稳定和神经元存活至关重要[9]。 图 7. Wnt 信号通路在细胞中的作用[9]。 Section.06 希望之光:M1 受体 ——潜在的“刹车”开关 面对这场多米诺骨牌式的灾难,是否还有干预窗口? 答案是肯定
 技术资料
技术资料暂无技术资料 索取技术资料





![Alpha fetoprotein / AFP antibody [1E8]](https://img1.dxycdn.com/2022/0328/492/9473457087988500453-14.jpg!wh200)
![Zika virus NS4B protein antibody [HL1664]](https://img1.dxycdn.com/2023/0605/803/4262020502311755661-14.jpg!wh200)
![CD52 antibody [HI186]](https://img1.dxycdn.com/2022/0328/177/5627427769029300453-14.jpg!wh200)



